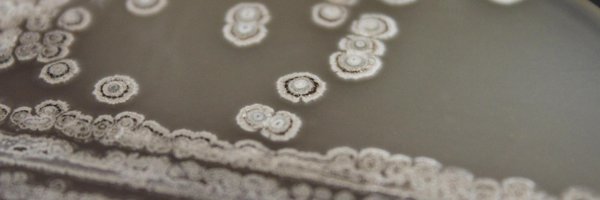
Smanski_Lab Profile Banner

Building Better Bugs
@Smanski_Lab
Followers
448
Following
160
Media
70
Statuses
421
Joined October 2015
Scientists have birthed a ‘super cannibal’ that never grows up. Could it be key to combating Australia’s cane toad menace?
theguardian.com
There’s quiet optimism that gene-edited ‘Peter Pan’ tadpoles could help control one of the world’s worst invasive species
0
3
3
I sat down for a break during my morning walk at #ICE2024Kyoto and this guy started croaking at me. How appropriate.
0
0
2
Great lineup of speakers for #ICBE25. Students and postdocs can still submit abstracts to be a part of it.
aiche.org
The International Conference on Biomolecular Engineering brings together researchers who are using quantitative approaches to advance the understanding and application of molecular biology. Presented...
0
3
3
We are excited to finally publish the unprecedented biosynthetic origins of enediyne natural products: iodinated polyynes! This transformative discovery is a huge milestone for these clinical antitumor antibiotics. @Kalkreuter @guichun98 @nchembio
https://t.co/oRDfTcKEkn
6
30
127
AmberBio is hiring: https://t.co/iDpCSnEpVf. I highly recommend looking into it if you want to work at a fast-moving startup with a creative and impactful technology. @themicrobeguy
0
1
2
Looking for a postdoc? We are currently hiring plant synthetic biologist to work on an exciting and collaborative DoE project.
2
6
13
Great work by Tepper, Maselko, et al. Fish that break down methylmercury!
Very excited to share our preprint demonstrating that animals can be engineered to bioremediate methylmercury! Amazing work by @Dr__Tepper
https://t.co/TXQaqWZ8SK
0
0
2
Trick or treaters aren't letting me leave the building to go teach.
1
0
12
Minnesota is dressing up like Christmas for Halloween. I think I have seen this movie.
0
0
0
Thanks @themicrobeguy for a great seminar on engineered trans-splicing. Great our alumni crushing it @umncbs
1
1
4
Putting this on the summer reading list. Looks exciting Basem.
🚨 Today, we’re thrilled to share our study expanding the gene editing toolbox to enable virtually any kind of edit in gene transcripts at the order of thousands of bases. A thread 🧵👇(1/n) https://t.co/zA4EyAVHFQ
0
0
5
At high ratios of male-to-female, (i.e., ratios that are expected for many mosquito biocontrol approaches), the females are pestered to the point where they no longer blood-feed, improving the performance of the biocontrol in an interesting and unexpected way!
For all those using genetic control based on the release of males… high male to female ratios may block disease transmission quicker than expected… check our preprint with videos…😅
0
0
4
If you cannot explain something in simple terms, you don't understand it.
715
9K
55K
I am proud of the work that Armando, Matt, and Adam published here, but even more excited for the complex systems engineering that these tools are enabling in the lab (more papers to come soon!) [2/2]
0
0
3
We did not set out to develop new #SynBio tools for plants, but when the existing tools weren't cutting it (or more specifically weren't expressing it), postdoc Armando Casas-Mollano decided we needed improved CRISPRa for plants. [1/2] https://t.co/UW105fBzO7
academic.oup.com
Abstract. CRISPR/Cas-based transcriptional activators have been developed to induce gene expression in eukaryotic and prokaryotic organisms. The main advan
3
31
124
I am proud of Armando's paper, but even more excited about the complex engineered systems that these tools are enabling (more papers to come soon!) [2/2]
0
0
0
I especially liked his blog on mouse models [ https://t.co/NRO7hw1IVh]. Making model organisms more predictive of the thing they are supposed to be modeling is a worthwhile goal of near-future Synthetic Biology (Engineering Biology?, what are we saying now?).
I love Niko's writing - I've been an avid reader of his for years and I'm lucky to get to work with him now at @AsimovBio. We have a bunch of cool things in the works, stay tuned!
0
0
1
See Szu-Yi Campbell (nee Hsu)'s work on applying Design of Experiments to metabolic pathway engineering in Metabolic Engineering. Interesting and unexpected impact on colony morphology (Jihaeng Li) and simulations to extend results (Adam Sychla)
1
3
6
If you’re interested in working at the forefront of quantitative mammalian cell engineering, we’re hiring for all types of roles @AsimovBio
https://t.co/iWRDxXseYd
@CBM_CDMO At Asimov, we're developing full-stack tools to advance therapeutics manufacturing, from host cells, to optimized genetic systems, to bioreactor process models. This partnership aligns with our goal to increase access to cell and gene therapies.
0
4
8